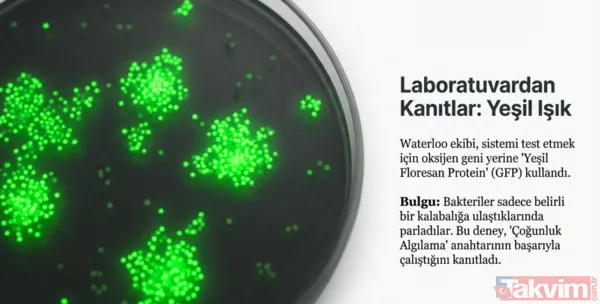
Kansere karşı mikro savaş: Bilim insanları tümörleri içten yiyen bakteri geliştirdi - 12

Waterloo Üniversitesi'nden bilim insanları, onkoloji dünyasında yeni bir tedavi yöntemi üzerinde çalışıyor. Geleneksel yöntemlerin aksine bu teknoloji kanserli hücreleri dışarıdan kuşatmak yerine kaleyi içeriden fethetmeyi amaçlıyor.

Tümörlerin Zayıf Noktası: Oksijensiz Çekirdek
Katı tümörler büyüdükçe, merkez bölgelerinde oksijen seviyesi ciddi biçimde düşer. Bunun nedeni hızla çoğalan kanser hücrelerinin mevcut kan damarlarının taşıyabileceğinden daha fazla oksijen tüketmesidir. Sonuçta tümörün merkezinde "hipoksik" yani oksijensiz bir alan oluşur. Araştırmacılar, bu doğal zayıflığı avantaja çevirmeyi amaçladı.

Toprak Bakterisinden Kanser Silahına
Bilim insanları, doğada yaygın olarak bulunan ve yalnızca oksijensiz ortamlarda yaşayabilen Clostridium sporogenes adlı bakteri üzerinde çalıştı. Bu özellik onu katı tümörlerin merkezleri için ideal bir aday haline getiriyor.

Bakteri tümöre ulaştığında:
Oksijensiz çekirdekte hızla çoğalıyor
Kanserli dokuyu içeriden parçalamaya başlıyor
Tümörü merkezden dışa doğru zayıflatıyor
Bu yaklaşım bağışıklık sistemi ve kemoterapinin ulaşmakta zorlandığı bölgeleri hedef alması bakımından önemli bir avantaj sunuyor.

Bakteri dış katmanlara ulaşamıyordu
Ancak bu yöntemin önemli bir sınırlaması vardı. C. sporogenes, tümörün oksijensiz merkezinde gelişebilse de dış katmanlara yaklaştıkça artan oksijen seviyesi nedeniyle hayatta kalamıyordu. Bu da bakterilerin tümörü tamamen yok edemeden ölmesine yol açıyordu. Araştırmacılar bu sorunu genetik mühendisliğiyle aşmayı hedefledi.